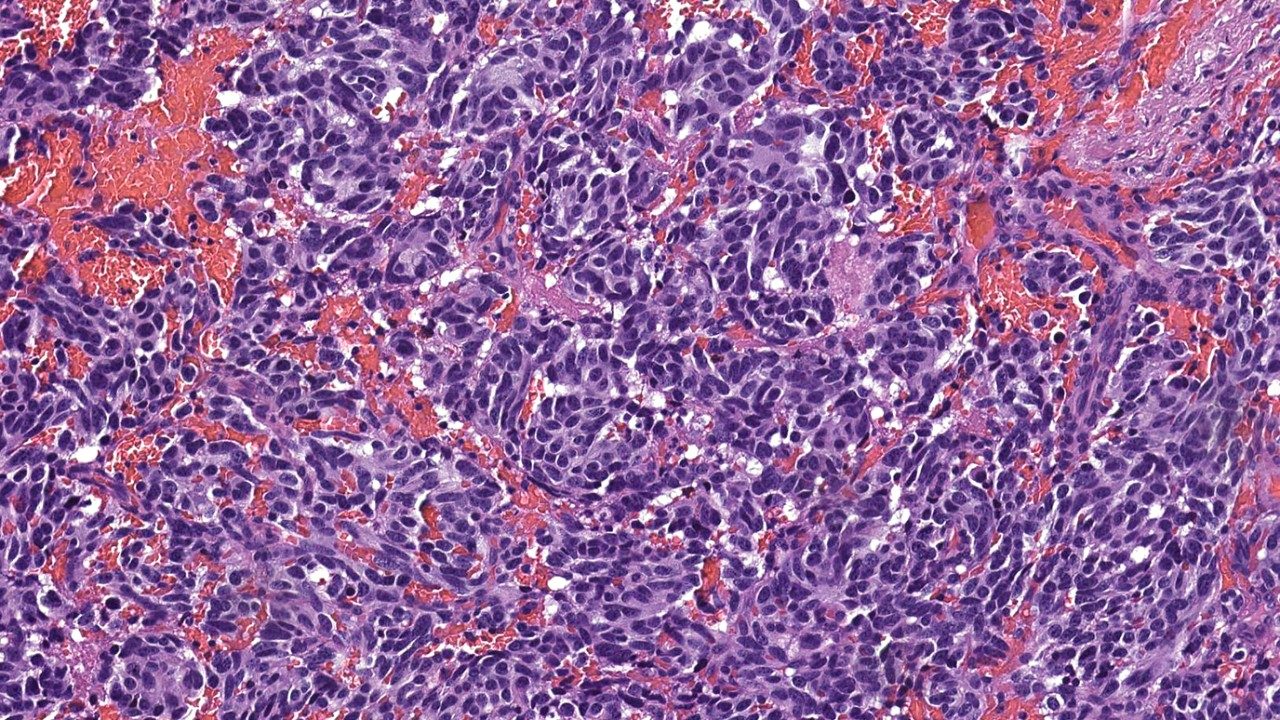

CAR NK cell therapy now an experimental treatment option for multiple cancers
CAR NK cell therapy bolsters the body’s innate ability to fight cancer by attaching molecules called chimeric antigen receptors (CAR) to natural killer cells (NK cells). These receptors allow the newly enhanced CAR NK cells to recognize targets on the surface of previously “invisible” cancer cells and attack them.
At MD Anderson, this novel form of immunotherapy was initially offered only through clinical trials to...

10 things to know about neuroendocrine tumors
About 12,000 people in the United States will be diagnosed with neuroendocrine tumors — sometimes called carcinoid tumors — each year. But...

Stomach cancer survivor back on her feet after heated chemotherapy clinical trial
Faye Hood was training for a half-marathon in 2017, when the active then-70-year-old received a stomach cancer diagnosis.
While she...
Why I chose MD Anderson for skull base tumor treatment
Until a few years ago, my father was the only person in my family who’d ever had cancer. In 1997, he was diagnosed with mesothelioma, which is almost always caused by exposure to asbestos.
My dad developed the disease in his lungs after working in the electrical services industry for 20 years. By the time he was diagnosed, the cancer had already spread to his brain. My father died of complications of mesothelioma in 1999, at age...


Inflammatory breast cancer survivor finds hope in clinical trial
I’m the kind of person who follows my gut. So, when I looked up my symptoms online and thought I had inflammatory breast cancer, I kept pushing...

Sharing hope is the most important part of my job as a nurse navigator
When most people hear the word “cancer,” they usually react with fear or distress. That’s why I’m so glad to work as a nurse navigator at...

Cardiothoracic surgeon: Compassion is MD Anderson’s secret ingredient
The way I practice medicine is heavily influenced by the fact that I’m a mother. Many of the same qualities that are useful in parenting my...

Pancreatic cancer survivor: 3 myths about MD Anderson
I live in Dallas, but when I was diagnosed with pancreatic cancer in June 2017, I chose to come to MD Anderson for my treatment. My husband...

3 things I’ve learned from my wife’s brain cancer relapse
Prior to my wife’s glioblastoma diagnosis in 2013, I traveled a lot for my job, both inside and outside the U.S. That arrangement worked out...

Breast cancer survivor: Watch for changes in your breasts
In late 2016, I was eating organic food, working out regularly and had never missed a mammogram. Yet, I still ended up with a breast cancer...

3 benefits of journaling for cancer patients and caregivers
Facing a cancer diagnosis or caring for someone during cancer treatment can be extremely stressful. And, when you’re dealing with stress,...

Lung cancer survivor: Targeted therapy clinical trial halted my stage IV disease
Until November 2018, I’d never been hospitalized before. So, the suddenness of my lung cancer diagnosis at age 65 that year caught me completely...

5 questions about bone health and cancer
Losing bone density is common as you age, when cells that help rebuild bones aren’t replaced as quickly. Because of this, your bones may become...
